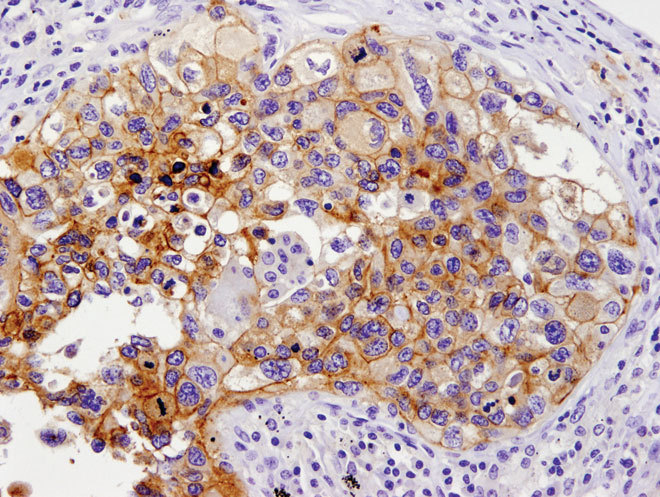

Advancing Immunology Research with CST's Cutting-Edge Antibodies and Assays
In Stock
$34.99
$29.99
Shipping and Returns Policy
- Deliver to United States » Shipping Policy «
- - Shipping Cost: $5.99
- - Handling time: 2-3 business days
- - Transit time: 7-10 business days
- Eligible for » Returns & Refund Policy « within 30 days from the date of delivery
Find similar items here:
cell signaling technology inc
- Advancing Immunology Research with CST's Antibodies and Assays
- Advancing Medical Diagnostics with CST's Novel Technologies
- Unveiling the Molecular Language of Cells Cell Signaling Technology's Breakthroughs
- Deciphering the Cellular Code Cell Signaling Technology's Breakthroughs
- Accelerate Your Research Cell Signaling Technology's Innovative Solutions
- Revolutionizing Drug Discovery with Cell Signaling Technology
- Illuminating the Cellular Matrix Cell Signaling Technology's Insight
- Unlocking the Secrets of Cellular Communication with CST
- Empowering Scientists to Decipher Cellular Networks
- Advancing Biosciences Cell Signaling Technology's Impact
-
Next Day Delivery by USPS
Find out more
Order by 9pm (excludes Public holidays)
$11.99
-
Express Delivery - 48 Hours
Find out more
Order by 9pm (excludes Public holidays)
$9.99
-
Standard Delivery $6.99 Find out more
Delivered within 3 - 7 days (excludes Public holidays).
-
Store Delivery $6.99 Find out more
Delivered to your chosen store within 3-7 days
Spend over $400 (excluding delivery charge) to get a $20 voucher to spend in-store -
International Delivery Find out more
International Delivery is available for this product. The cost and delivery time depend on the country.
You can now return your online order in a few easy steps. Select your preferred tracked returns service. We have print at home, paperless and collection options available.
You have 28 days to return your order from the date it’s delivered. Exclusions apply.
View our full Returns and Exchanges information.
Our extended Christmas returns policy runs from 28th October until 5th January 2025, all items purchased online during this time can be returned for a full refund.
No reviews yet. Only logged in customers who have purchased this product may leave a review.
